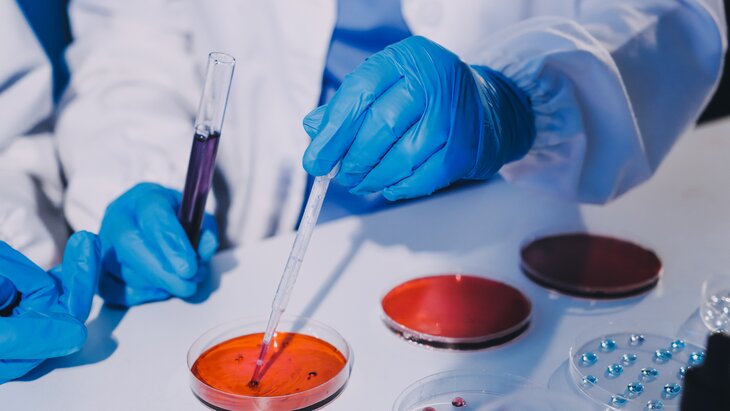

05 июня 2025, 11:59
НаукаУченые из Индии создали материал, предотвращающий тромбоз без риска кровотечений
Фото: 123RF/armmypicca
Исследователи из Индийского института науки разработали вещества, способные предотвратить избыточную активацию тромбоцитов в организме. Результаты их работы опубликованы в журнале Angewandte Chemie International Edition.
Ученые отметили, что тромбозы возникают в связи с тромбоэмболией легочной артерии (ТЭЛА) или COVID-19 – при таких патологиях происходит окислительный стресс и повышение уровня активных форм кислорода (ROS) в организме.
В ходе исследований специалисты создали сферические нанозимы из пентоксида ванадия (V2O5). Они имитируют действие глутатионпероксидазы, природного антиоксидантного фермента, нейтрализуя ROS и контролируя процесс формирования тромбоцитов в организме.
Эффективность материала была доказана экспериментальным путем на мышах с моделью ТЭЛА – нанозим способствовал уменьшению тромбообразования и повышению выживаемости грызунов.
По сравнению с традиционными антикоагулянтами, созданные учеными вещества оказывают воздействие только на патологические процессы и не вызывают кровотечения. В дальнейшем специалисты хотят изучить эффективность нанозима в профилактике ишемического инсульта.
Ранее стало известно, что российские ученые разработали соединение, останавливающее развитие эпилепсии.




















